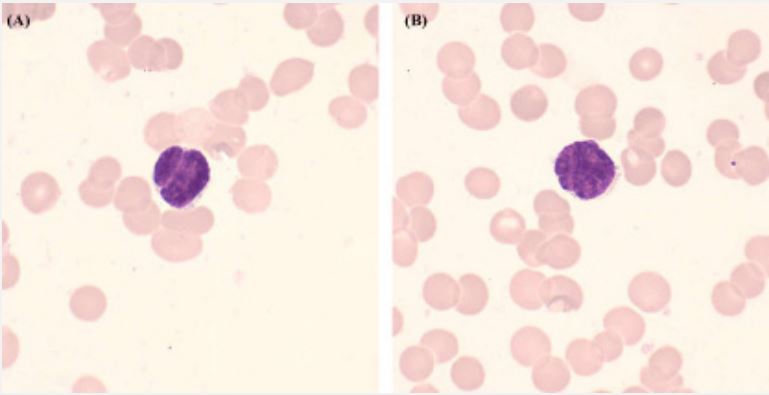

Clinical Image
Volume 3, Issue 3
A Case of Lymphoplasmacytic Cell Lymphoma Characterized by Marked Nuclear Fission and Brain Gyrus Nuclei of Lymphocytes
Zailin Yang; Yu Peng; Longrong Ran; Xuelian Wu; Shuang Chen*
Department of Hematology-Oncology, Chongqing Key Laboratory of Translational Research for Cancer Metastasis and Individualized Treatment, Chongqing University Cancer Hospital, Chongqing, China.
Corresponding Author :
Shuang Chen
Email: 644491787@qq.com
Received : Feb 20, 2024 Accepted : Mar 25, 2024 Published : Mar 29, 2024 Archived : www.meddiscoveries.org
Citation: Yang Z, Peng Y, Ran L, Wu X, Chen S. A Case of Lymphoplasmacytic Cell Lymphoma Characterized by Marked Nuclear Fission and Brain Gyrus Nuclei of Lymphocytes. Med Discoveries. 2024; 3(3): 1138.
Copyright:© 2024 Chen S. This is an open access article distributed under the Creative Commons Attribution License, which permits unrestricted use, distribution, and reproduction in any medium, provided the original work is properly cited.
Description
A 67-year-old male was admitted to the hospital due to fatigue and thrombocytopenia. Peripheral blood cells analysis showed the white blood cells count of 2.99 × 109 /L, red blood cell (RBC) count of 2.08 × 1012/L, platelet count of 15 × 109 /L. β2- microglobulin of serum was 5.50 mg/L. Whole-body positron emission tomography-computed tomography suggested altered reactivity in the lymph nodes of the bilateral neck. Morphological examination of bone marrow (BM) indicated the presence of abnormal smaller lymphocytes, accounting for 12.5% of the total nucleated cells. Strikingly, nuclear fission or brain gyrus nuclei were prominently observed in all abnormal lymphocytes (Figure 1, original magnification 1000×; Wright–Giemsa stain). The proportion of plasma cells was 0.5%, and no morphological abnormalities were observed. Additionally, some RBCs were exhibited a rouleaux arrangement. Flow cytometry analysis of BM identified 16.12% of κ-restricted B lymphocytes expressing CD5- , CD10- , CD19+ , CD20+ . A minimal proportion of 0.03% plasma cells with κ/λ ratio of 1.07. Consistent results were confirmed by immunohistochemistry in the BM biopsy. Immunofixation electrophoresis revealed abnormal monoclonal bands in the IgM and κ lanes. Furthermore, mutations of MYD88 (L265P), CXCR4 (T318fs), and TP53 (R306X) were identified through next-generation sequencing analysis. A diagnosis of lymphoplasmic cell lymphoma/waldenström macroglobulinemia (LPL/WM) was established.
In conclusion, we present a new case of LPL/WM characterized by the presence of numerous lymphocytes with marked nuclear fission and brain gyrus nuclei in the BM.
Acknowledgement: None.
Conflict of interest: The authors declare that they have no conflict of interest.
Ethical agreement: The patient written informed consent was obtained from the individuals for the publication of any potentially identifiable images or data included in this article.
Funding: This work was supported by the Chongqing Medical and Pharmaceutical Biotechnology Association Research and Cultivation Project (Grant Number cmba2022kyym-zkxmQ0008).